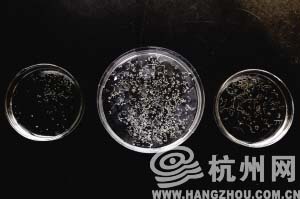

浙江省医学科学院专业人员从黄鳝身上取出的寄生虫。左一为颚口线虫。

显微镜下的颚口线虫

颚口线虫在患者皮肤下的游走路径
浙江省医学科学院寄生虫病研究所是我省乃至全国最顶尖的寄生虫病研究机构之一,经常有来自全国各地的寄生虫病疑难病例到他们这里要求帮助确诊。从2008年开始,他们研究所陆陆续续接待了上百个从全国各地慕名而来的奇怪病人。今年以来就接待了六七十个,其中浙江患者有二三十个。
这些患者症状都非常相似:患者皮下出现红肿游走性包块,新旧两包块间,可以看到一条像虫子爬过一样的匍行疹,还伴有发热等。浙江省医学科学院寄生虫病研究所免疫诊断室负责人干小仙研究员和她的研究团队研制出了一种检测试剂,最终高度怀疑这些患者体内染上了颚口线虫——这是一种来自国外的要命寄生虫。对症下药后,症状消失了。
这两年,干小仙老师和她的团队一直在追踪颚口线虫的足迹,为了确定感染源,干老师前几天到市场上买了一些黄鳝。解剖分离的结果,让她也大吃一惊:平均每斤黄鳝体内居然有25条颚口线虫。
每斤黄鳝检出25条颚口线虫
“由于这次的课题主要是为了研究颚口线虫,所以我们特地去平时病例比较多发的地方采购黄鳝,杭州、外地都有,一共去了五六个农贸市场,采购了10斤黄鳝,每斤25-30块钱。”干老师说。
具体实验过程如下,先把黄鳝解剖,取出肌肉和内脏,然后再把它们分离开——之所以要分离,是为了看看哪个部位的寄生虫比较多。
然后再把黄鳝的肝、肠和肌肉分别加入清水用机器打散。
打散后,在碎组织中加入消化液(消化液包含胃蛋白酶、氯化钠、稀盐酸和水,模拟的是胃液的成分),放入37℃温箱进行加热(37℃模拟的是人体胃部的温度),每10分钟搅拌一次,孵育约4小时。
孵育后再取出,就差不多类似于被人的胃部消化过的状态了。
接着再把液体加入生理盐水,放入沉淀杯进行沉淀等。最后把沉淀物取出,放在解剖镜上用显微镜把虫体一条条分离出来。
“结果,总共分离出了整整250条活的颚口线虫。”
这也是第一次从杭州市场上销售的黄鳝中检出颚口线虫,以前只是高度怀疑。
实验还发现,颚口线虫不但存在于黄鳝的内脏中,也存在于肌肉中,其中肝脏位置最多。
颚口线虫会在体内任何部位游走
干老师说,颚口线虫原本主要分布在亚洲东南部国家,泰国、日本人喜欢生食水产品,感染比例最高,中国以前很少有感染颚口线虫的病例报告,1957年至2005年,全国仅报告病例37例,其中浙江省仅1957年、1981年、2002年各报告一例。
颚口线虫的可怕之处在于,它可以在人体内存活好几年,而且会全身游走,游到哪里,就会对哪里的组织器官带来损伤——除了由于虫体游走带来的机械损伤,还有它分泌的毒素会带来病害。颚口线虫的致病部位极其广泛,几乎遍及全身各处——
如果到消化道,就会表现出腹痛、腹泻、便秘等;到胸部,可引起胸膜炎;到肺部可产生咳嗽和胸痛等症状;到喉部可导致喉头水肿、呼吸困难;到唇舌可引起说话困难;到耳部可引起听力障碍;到膀胱系统可出现血尿、痒痛等;到子宫可引起慢性宫颈炎。如果是到眼睛,可能失明。如果钻到大脑里或心脏,就会导致死亡。
“不过这个病确诊后不难治,只要吃驱虫药就可以了,国际上治疗颚口线虫病有一种特效药,叫伊维菌素,美国产的,只要连吃2天,基本可以杀灭虫子。也可以吃阿苯达唑(肠虫清),不过吃的剂量很大,要连吃20天,效果一般,副作用也要大一些。”
干老师说,虽然不难治,但得了这个病最难的是确诊,不要说小的诊所,就是大的医院也没有这个诊断技术,目前在国内还只有浙江省医学科学院能用试剂检测出颚口线虫。
“我们申报的‘颚口线虫病免疫诊方法的建立与应用’课题,已经获得省卫生厅的立项,计划用两年半的时间,从黄鳝和泥鳅体内收集颚口线虫的抗原,用来制作更有效的检测试剂。”
干老师说,今年,她们这里的检测试剂还比较紧张,明年开始,检测试剂就比较充足了,将免费为市民开放检测。


